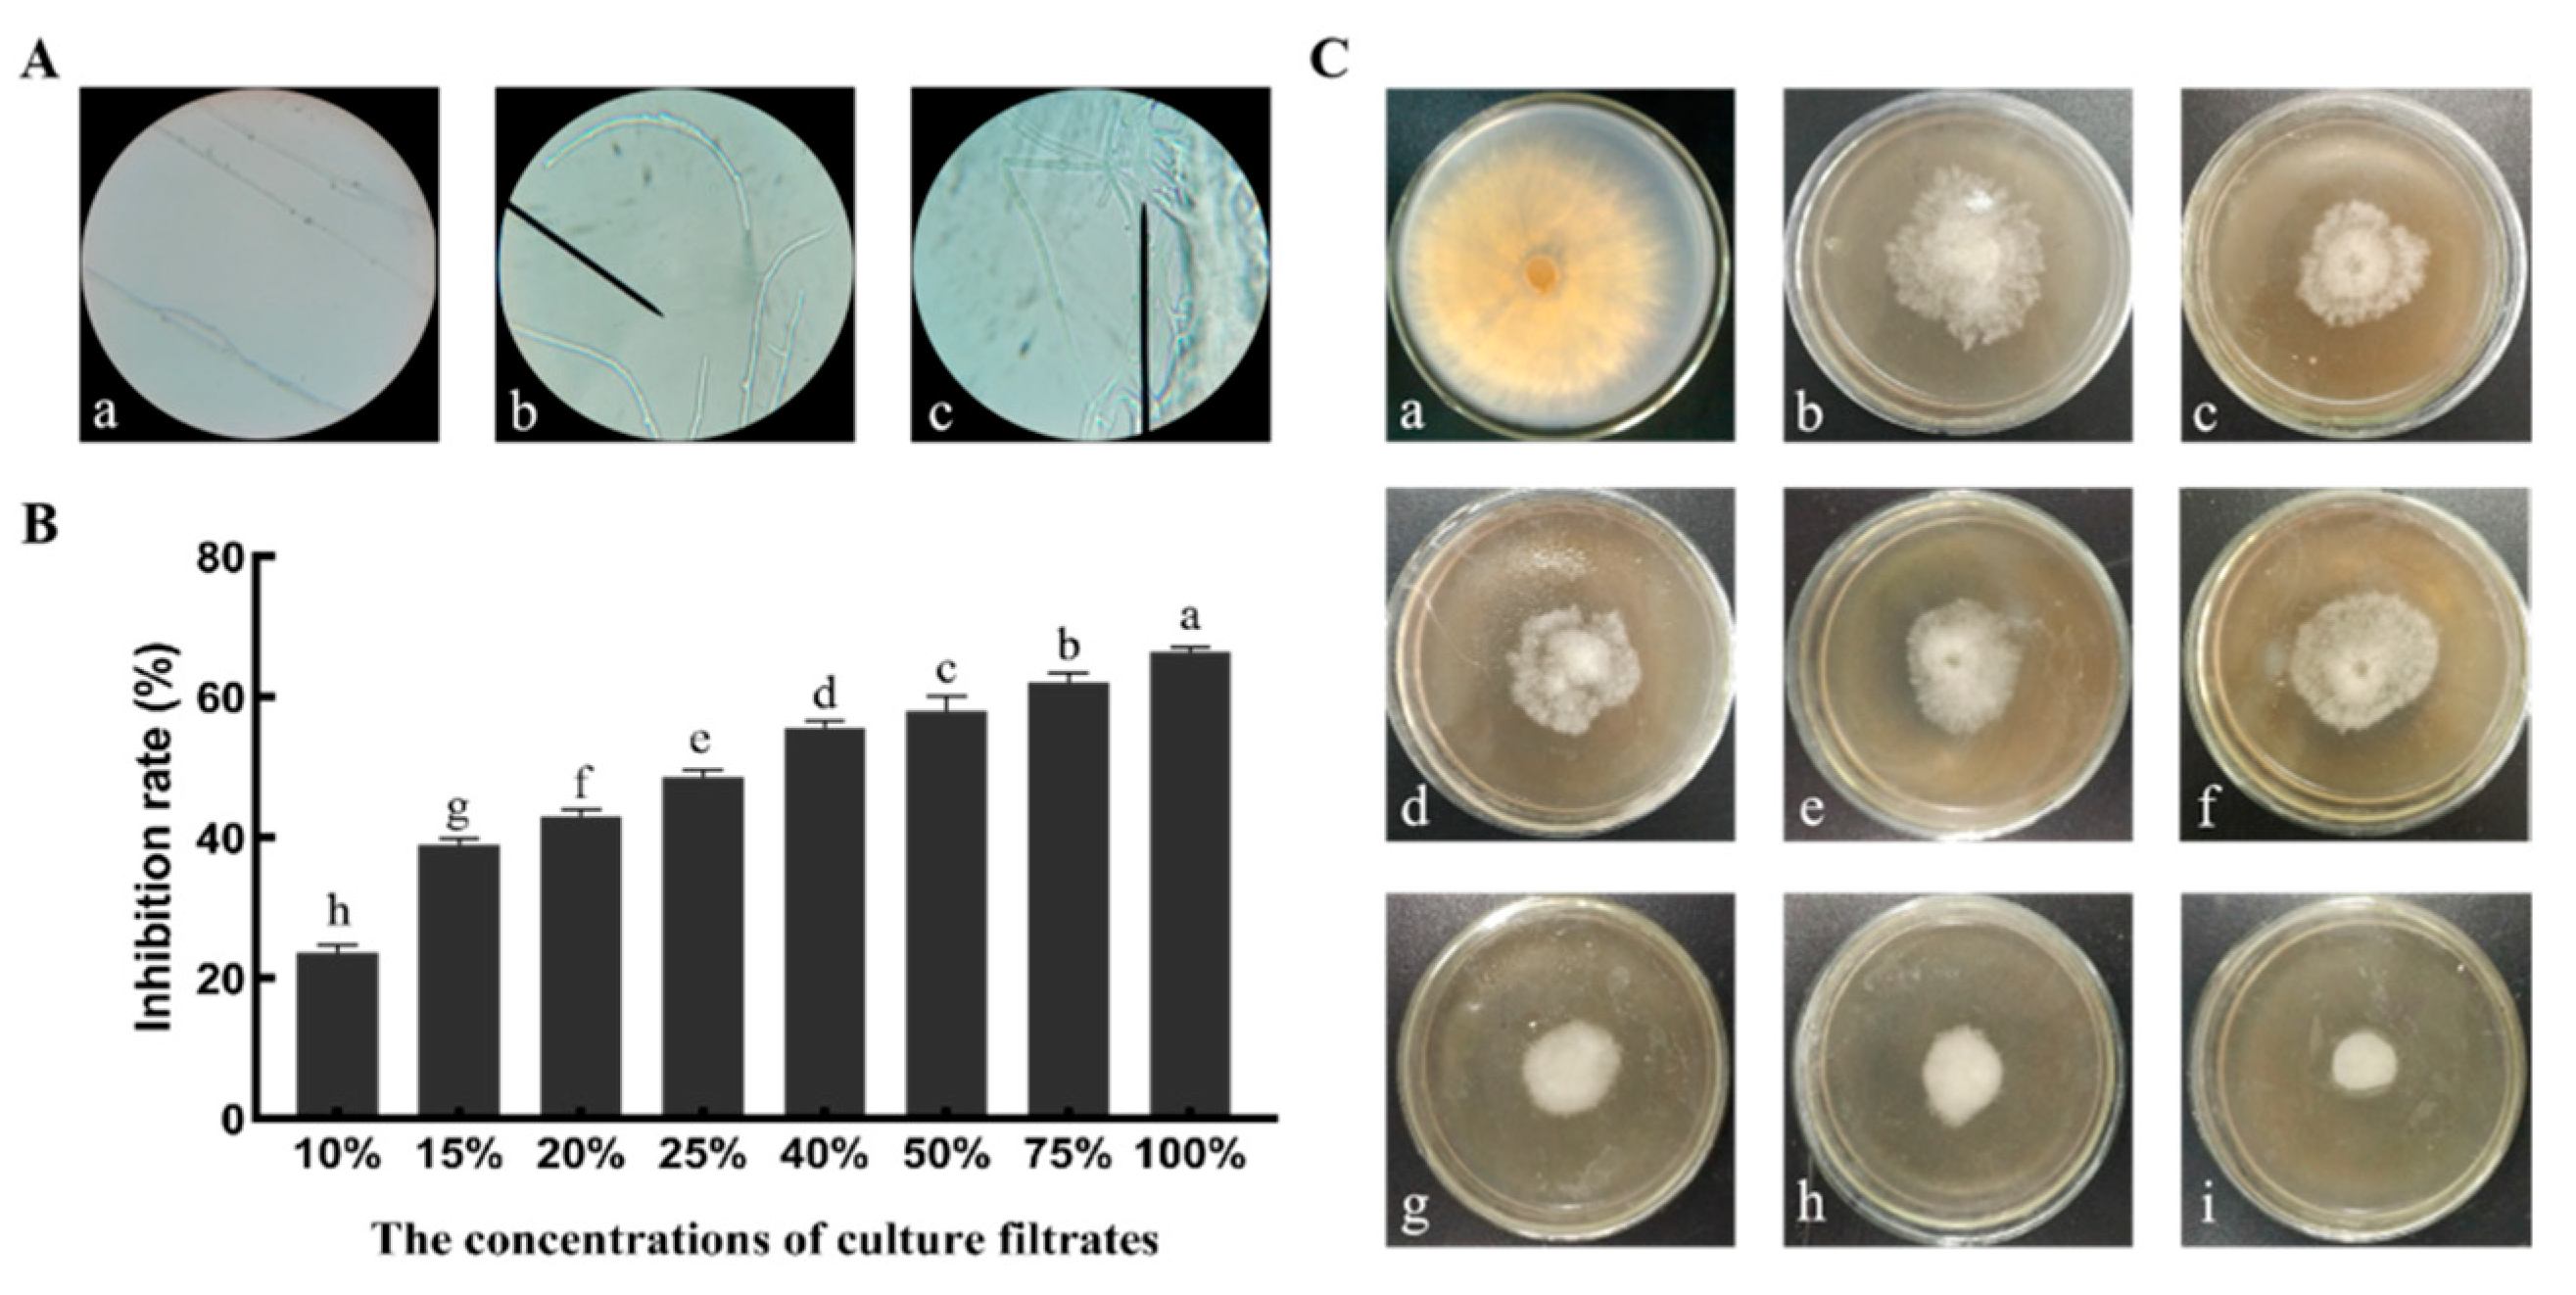
Microorganisms 10 01682 g006 550

1. Introduction
Wheat (
Triticum aestivum L.), the third most important food crop, is widely planted around the world [
1]. With downward economic pressure and the impact of COVID-19, the global demand for wheat will increase with the increase of environmental pressure [
2,
3]. Wheat production is seriously affected by various abiotic and biotic stresses. Among plant fungal diseases, wheat sharp eyespot is one of the most destructive diseases that affects wheat growth and yield and grain quality [
4]. The soil-borne fungus,
R. cerealis, is a major causal pathogen of wheat sharp eyespot.
R. cerealis doesn’t produce asexual spores, so it exists in the soil as either a vegetative hyphae or sexual sclerotia [
5]. The pathogen can enter the plant system through basal stems and basal sheaths, penetrate the cell wall, and eventually reach the interior of the cell to destroy the plants [
6]. The transport system in wheat susceptible plants is impeded and they can be infected by the pathogen at all stages of growth and development [
7]. Therefore, the fungus causes significant damage to the wheat and is a threat to world wheat production.
In China, chemical pesticides and field management are widely used in agriculture and forestry to control diseases. However, due to the pathogen’s natural persistence and various environmental factors in field management, the prevention and control effects are not ideal [
8]. Many chemical pesticides, such as diniconazole, carbendazim, and thiophanate, can effectively reduce the occurrence of wheat sharp eyespot [
9]. However, environmental pollution and resistant microbial strains induced by the overuse of chemical pesticides are growing problems. In response to this demand, biological control has become widely used as an environmentally-friendly and species-specific method for fungi disease control [
10].
In recent years, many antagonistic microorganisms have been applied in the biocontrol of fungi diseases of agricultural plants [
11]. More and more microbial strains are continuously being screened and isolated. Bacterial genera, such as
Bacillus,
Streptomyces, and
Pseudomonas, are often used for the biocontrol of some fungal diseases [
12,
13,
14]. Several reports demonstrate that some of the bacteria can also promote plant growth [
15]. Research of
Bacillus agents has shown that they resist fungal pathogens through antagonism, niche space and nutrients competition, and host resistance induction [
16,
17]. The biocontrol effects of certain strains are mainly relevant to their production of cyclic lipopeptides (CLPs), which exhibit excellent antifungal properties [
18,
19].
B. circulans,
B. sphaericus,
B. subtilis,
B. licheniformis, etc. also have been used as biological control agents against different fungi diseases for a long time [
20]. However, the number of
B. mojavensis bacteria screened and isolated was less than the number of
B. subtilis. According to the relevant literature,
B. mojavensis can produce VOCs that act as plant growth modulators [
21].
B. mojavensis has been reported to decrease fumonisins accumulation in maize [
22]. Moreover,
B. mojavensis can also produce cyclic lipopeptides (CLPs), which include iturin, surfactin, and fengycin [
23,
24]. Therefore, it is necessary to isolate and characterize different biocontrol strains.
This study aims to isolate and identify the antagonistic strains against R. cerealis and optimize the culture conditions for improving its antifungal activity. The antifungal spectrum, active substances, growth promotion, control efficacy, and animal safety were further analyzed, which laid the foundation for the development of effective biological fungicides against wheat sharp eyespot.
2. Materials and Methods
2.1. Materials
Soil samples were collected from the rhizosphere soil of wheat in Zhengzhou, Henan. Soil was loamy cinnamon soil (according to Chinese soil classification) with a pH of 7.9, an organic matter content of 1.21%, and a nutrient content of available N of 0.078%, available P of 7 ppm, and available K of 215 ppm. (
www.soil.csdb.cn, accessed on 16 June 2021). A five-point sampling method was used to collect the rhizosphere soil samples (0–20 cm). After the wheat were dug out, the roots were carefully shaken to remove the loosely adhering soil, and the remaining attached soil was carefully collected as rhizosphere soil using a sterile brush.
Six plant pathogens, Rhizoctonia cerealis, Fusarium graminearum, Bipolaris sorokiniana, Alternaria solani, Bipolaris maydis Shoem, and Fusarium oxysporum, were stored at −20 °C in our laboratory. Pathogens were cultured on PDA medium (20 g of glucose, 200 g of potato, 15 g of agar, 1000 mL of sterile water). The culture conditions followed the methods of Min-Jeong Kim with appropriate modifications [
16].
Wheat seed (Yumai 49) was provided by Henan Academy of Agricultural Sciences, which was widely planted in the Huang-Huai wheat production area.
KM mice (Certificate of conformity: SCXK 2015-0004) were purchased from the Henan experimental animal center with weights between 18–22 g, SPF grade, and in good health.
2.2. Isolation and Screening of the Antagonistic Bacteria
Bacteria were isolated from soil by serial dilution method. Every soil sample was serially diluted up to 10
−8 with sterile distilled water. Subsequently, 100 μL of the diluted soil resuspension was spread on Luria–Bertani (LB) medium (5 g of yeast extract, 10 g of peptone, 10 g of NaCl, 1 L of sterile water, pH 7) plates and incubated at 37 °C for 48 h. The colonies with different morphologies were selected for purifying and testing the antifungal activity by the plate confrontation method [
25]. Antagonistic strains inoculated into LB medium were cultured under agitation at 180 r/min at 37 °C for 2 days. Then, culture filtrate was prepared by filtering the supernatant of the culture through a 0.22-µm filter. The mycelial growth rate method was used to determine the inhibition rate of B1302 culture filtrate [
26]. LB plates without culture filtrate were taken as the control. The process was repeated three times. The formula for the inhibition rate is as follows:
where A is the mycelial radial diameter of the pathogen in the control plate and B is the mycelial radial growth diameter of the pathogen in the treatment group.
2.3. Identification of the Antagonistic Strain B1302
Strain B1302 was cultured on Luria–Bertani (LB) medium (5 g of yeast extract, 10 g of peptone, 10 g of NaCl, 1 L of sterile water, pH 7) at 37 °C for two days. A morphological, physiological, and biochemical analysis were performed, including colony morphology, size, color, transparency, carbon source utilization, gelatin lignification, starch hydrolysis, glucose consumption, oxidase reactions, and nitrate reduction [
27].
A sequence analysis of 16S rDNA was used for molecular identification. Genomic DNA was extracted from the strain according to the method of Zakry et al. [
28]. The 16S rDNA sequence was amplified by PCR using the universal primers, 16SF (5′-AGAGTTTGATCATGGCTCAG-3′) and 16SR (5′-ACGGTTACCTTGTTACGACTT-3′) and sequenced by the Sangon Biotech Co., Ltd. (Shanghai, China) [
29]. Then, the sequence was analyzed through the BLAST tool on NCBI website (Bethesda, MD, USA;
http://www.ncbi.nlm.nih.gov/Blast, accessed on 29 July 2021) and the nearest neighbor of the 16S rDNA sequence was determined. A phylogenetic tree was constructed by the neighbor-joining tree algorithm using a bootstrap value of the MEGA7 [
30].
2.4. Detection of Antimicrobial Spectrum for B1302
The antagonistic activity of
B. mojavensis B1302 culture filtrate towards different pathogens was tested using the mycelial growth rate method, as described previously [
26]. The test was repeated three times.
2.5. Culture Conditions
A single factor method was taken to determine the optimal components of medium. The basic cultural conditions were 30 °C, 1% of inoculum, pH 7, 180 rpm, and 72 h. Various media with different components were used to test the optimal media and culture conditions for improving the antifungal activity. LB medium was supplemented with different carbon, bran density, nitrogen sources, soybean meal concentration, and inoculum amount, after which seed liquid was inoculated into the medium and incubated on a shaker at 180 rpm at 28 °C for 12 h. The effects of various pHs (6.0, 6.5, 7.0, 7.5, and 8.0) and cultivation times (48, 60, 72, 84, and 96 h) on the inhibition rate were then evaluated [
27]. The experiment was repeated three times.
2.6. Selection of Significant Variables for Culture Filtrate Antifungal Activity by Plackett–Burman Design
The Plackett–Burman statistical design is an efficient method for screening and identifying the significant variables among a large number of variables that have significant effects on the process [
31,
32]. The main factors were screened from the seven factors (wheat bran, soybean meal, pH, temperature, speed, inoculation amount, and cultivation time) that influenced the fermentation culture conditions when the inhibition rate (Y) was taken as the response value. For screening out the most important factors as soon as possible, each factor took two levels, the level of ‘1′ and ‘−1′. The test factors and levels are shown in
Table 1. The process was repeated three times.
2.7. Optimization of the Selected Significant Variables by Box–Behnken Design
The Plackett–Burman test was designed to identify three main factors affecting the culture conditions of antagonistic bacteria B1302. The Box–Behnken test design was applied to the 3 factors for 3 different levels (high (+ 1), medium (0), low (− 1)) for the response surface test, including 5 central tests and 12 factorial experiments [
33]. The test factors and levels are shown in
Table 2. Design-Expert 8.0.6 (Stat-Ease, Inc., Minneapolis, MN, USA) was used to analyze the regression equation of the response values of the 17 test points to obtain the optimal culture conditions for the antagonistic bacteria B1302. The process was repeated three times.
2.8. Antagonistic Activity of B1302 Culture Filtrates
The effect of B. mojavensis B1302 culture filtrates on the hyphal growth of R. cerealis was observed using optical microscopy. After pathogens were cultured in PDA medium with culture filtrates at 27–28 °C for 7–10 days, the hyphae were observed and recorded at a magnification of 10 × 20.
Antifungal activities against pathogens were performed by the mycelial growth rate method, as described previously. The final concentrations of B1302 culture filtrates ranged from 10%, 15%, 20%, 25%, 40%, 50%, 75%, and 100% using the LB culture dilution. The LB culture medium without culture filtrate was set as the control. After inoculation of the fungal mycelia onto the center of the solid medium, the dishes were incubated in the dark at 28 ± 0.5 °C. The experiment was repeated three times. When the fungal mycelium reached the edges in the control plates, the antifungal activities were calculated.
2.9. Extracellular Enzyme Activity and Assays for Detection of PGP Abilities
The enzyme activity was determined by the DNS method according to Nongnat et al., with some modifications, with glucose being a standard for the calibration curves [
34]. Chitinase and β-1,3-glucanase activity was quantified and calculated in three repetitions.
The protease activity was determined using a modified Folin method [
35]. To measure protease production in the culture filtrate, tyrosine was taken as the standard and repeated three times. The amount of enzyme required to produce an equivalent of 1 g of tyrosine per minute is defined as an enzyme viability unit (U).
The ability of the strain to grow in nitrogen-deficient media was detected using Ashby’s N-free mannitol agar [
36]. A 200-μL aliquot of fresh culture was inoculated on the agar medium and cultured at 28 °C for 48 h. The development of visible growth on the plates was observed. The P concentrations were measured using the molybdenum antimony colorimetric method [
37]. The culture filtrate was incubated under agitation at 180 r/min at 28 °C for 4 days, followed by centrifugation at 10,000 r/min for 15 min at 4°C. After reaction with molybdenum-antimony solution, the P concentration was calorimetrically determined at 700 nm. Indole-3-acetic acid from the strain was determined by the colorimetric method using Salkowski reagent [
38]. The tests were repeated three times.
2.10. Evaluation of B. mojavensis B1302 Culture Filtrate on Wheat Growth
Strain B1302 was cultured in LB medium for 48 h, then centrifuged at 4000 rpm and resuspended with sterile water to adjust the final cell concentration to 1 × 10
8 CFU/mL. Seeds of Yumai 49 soaked with different liquids (culture filtrate, fungicides, and sterile water) were planted in three pots, respectively. Then, the plants were grown in the same light intensity (4000 lx) and at a light:dark (L:D) ratio of 14 h:10 h. The triadimefon, carbendazim,
Validamycin·Bacillus, and sterile water were set as positive and negative controls, respectively. The germination rate, height, and fresh weights of seedlings and roots were measured [
39]. Each treatment was repeated three times.
2.11. Assay of B. mojavensis B1302 Culture Filtrate on Disease Control
In potted plants experiments, antagonistic strain B1302 were examined for their biocontrol efficacies against wheat sharp eyespot. Triadimefon, carbendazim,
Validamycin·
Bacillus, and sterile water were used as positive and negative controls, respectively. Triadimefon, carbendazim,
Validamycin·
Bacillus, sterile water, and cultivation liquid of the B1302 bacterial strain suspension were sprayed separately onto the wheat. The potted plants experiments were repeated three times. After infection with the disease in the wheat in the control group, the incidence of wheat sharp eyespot was statistically analyzed according to a scale ranging from 0 to 9 (0 = 0%; 1 ≤ 5%; 3 = 6–15%; 5 = 16–25%; 7 = 26–50%; and 9 ≥ 50%). The disease index and control efficacy were calculated as follows [
40]:
2.12. Toxicological Evaluation in Mice
An optimal cultivation medium and conditions were used to prepare the culture filtrate. The culture filtrate was filtered, concentrated, dried, ground, and sterilized to make powder.
Twenty healthy KM mice were randomly divided into two groups, with ten males and ten females in each group. Animal rooms were maintained at a temperature of 20–22 °C with a relative humidity of 40–70%, 12 h light/dark cycle and air ventilation at 18 times per hour. All animal studies protocols were approved by the Ethical Committee of Henan University of Technology, and all operations accorded with the guidelines and regulations of Henan University of Technology.
A maximum tolerated dose (MTD) study was carried out on healthy KM mice according to the method of Lu et al. [
41]. The KM mice were orally administered with the initial 0.2 mL of 50 mL/kg culture filtrate powder and with the same amount of sterile water as the control group. The weights of the mice in each group were weighed on day 0, 2, 4, 8, and 14, respectively; the poisoning performance and death of the mice were observed; the changes in the fur, eyes, limb activities, and behavior of the mice were recorded; and symptoms of convulsion, diarrhea, salivation, lethargy, and coma were noted [
42].
Blood assays were performed to determine the glutamic-pyruvic transaminase, glutamic-oxalacetic transaminease, total bilirubin, urea nitrogen, and serum creatinine levels by biochemical analyzer. Additionally, the KM mice were dissected, and organs (heart, liver, spleen, kidneys, and lungs) were collected and examined. The relative organ weight of each organ was then calculated [
43].
All tests were repeated three times.
2.13. Statistical Analysis
A statistical analysis of the data was performed using the Sigma statistical software (SPSS 22.0, IBM, Chicago, IL, USA). The results were expressed as the mean ± SE. The statistical significance was determined by a one-way analysis of variance (ANOVA) and the post hoc test–least square difference (LSD) test. Differences were considered significant at p < 0.05.
4. Discussion
Biological control agents can prevent plants from pathogens. Among the many advantages of biological control agents is their environmental-friendliness [
44]. Common root rot (
Fusarium) and wheat sharp eyespot (
R. cerealis) are economically important diseases in global wheat [
45]. Isolated microbes from the environment, such as soils or plants, are often the first step toward biological effects. In the present study, we screened 25 strains for antagonistic effects against bacteria from soil samples, and 1 of these showed high antagonism against
R. cerealis. Then, the biochemical, physiological, and phylogenetic analyses of the 16S rDNA gene sequences confirmed that strain B1302 was
B. mojavensis. During the biocontrol of plant diseases, the screening of single resistant strains still mostly dominates. Hena Jamali et al., isolated
Bacillus subtilis RH5 from saline soil, which exhibited antifungal activity to the fungal pathogen,
R. solani [
46]. Zhao et al., isolated
Bacillus subtilis strain SG6 from wheat kernels and plant anthers against
F. graminearum [
47]. In the present study, by using confronting incubation, strain B1302 exhibits different degrees of inhibition for
R. cerealis, F. Graminearum, B. sorokiniana; A. solani, B. maydis Shoem, and
F. oxysporum. Among them, it exhibited stronger antifungal activity against
R. cerealis and showed broad-spectrum antifungal activity.
Nevertheless, medium composition strongly influenced microbial growth and the accumulation of metabolic products, and optimizing these parameters can improve bacterial efficiency. The single-factor method and response surface methodology (RSM) were the optimization techniques employed. Different carbon sources were used as carbon sources for antimicrobial substance production. Our results indicated that wheat bran fulfills the requirement of a carbon source and acts as the most significant substrate. Moreover, the type of nitrogen source is as equally important as the nutritional requirements of the organism. In this study, soybean meal was found to be the most effective for antifungal activity. Coronel-León et al., reported that the maximum antimicrobial substance of
B. licheniformis AL1.1 was obtained using 1.5% glucose [
48]. We also found that the ideal concentration of wheat bran is 13.2 g/L and the concentration of soybean meal is 14.1 g/L, which can reach better antifungal activity. Moreover, the inoculation volume directly affects the microbial cultivation efficiency. Antifungal activity will be most effective when the inoculation amount of bacteria reached 1.5 × 10
8 CFU/mL. Finally, the results proved that cultivation pH and time also affected antimicrobial substance production. A pH of 7.50 and cultivation time of 72 h, which had the best efficiency, is ideal. Based on the above results, we further optimized the cultivation medium formula with an orthogonal test. In the present study, the significant variables necessary for the enhancement of antimicrobial substance production were selected using the Plackett–Burman design. The RSM applied to the optimization of antimicrobial substance production in this investigation suggested the importance of a variety of factors at different levels. Overall, it can be concluded that optimization medium was more favorable for significant bacterial growth.
A study of the antifungal ability and the change of mycelial morphology of the pathogen was carried out in the present study. It is generally known that inhibition of hyphal growth is the main pattern of
Bacillus spp. strains against
R. cerealis. Yang et al., reported that
Bacillus subtilis strain YB-05 changed the mycelium of pathogen GGT-007, which were characterized by enlarged hyphae, abnormal shape, vesicles, distortion, or empty cells devoid of cytoplasm [
49]. Saoussen Ben Khedher et al., also indicated that
Bacillus subtilis V26 also led to the swelling and deformation of
Botrytis cinerea hyphae [
50]. The result showed that B1302 culture filtrates significantly exhibit inhibition for
R. cerealis and a concentration-dependent ability in vitro. Through light microscopy, we also found that B1302 culture filtrates can lead to abnormal hyphae growth, as well as hyphae that appear broken and shriveled in appearance.
The report indicates that
Bacillus spp. strains differ in their capacity to produce and secrete bioactive metabolites, even if they belong to the same species [
51]. For the mode of action of
Bacillus spp. with pathogenic bacteria, it is usually the ability to produce some extracellular enzymes (such as protease, chitinase, β-1,3-glucanase, and cellulase) that destroys the cellular structure of the pathogenic bacteria. Nevertheless,
Bacillus spp. still have the ability to produce PGP activity to promote crop growth. Given these outstanding abilities, researchers have progressively studied the genus
Bacillus. Zhou et al., reported that
Bacillus cereus YN917 had produced IAA, ACC deaminase, siderophores, protease, amylase, cellulase, and β-1,3-glucanase, and harbored mineral phosphate decomposition activity [
52]. Ei Mon Myo et al., proved that
Bacillus velezensis NKG-2 produced chitinase, cellulase, β-glucanase, IAA, and siderophore [
53]. It is reported that different genera have different enzyme production capacities. In the present study,
B. mojavensis strain B1302 produced extracellular enzyme activity and various PGP substances, such as, β-1,3 glucanase, protease, chitinase, and IAA, and has nitrogen-fixation, phosphorus-solubilizing activity, which helps plants to survive under
R. cerealis infection. Similarly, the production of IAA and nitrogen-fixation, phosphorus-solubilizing activities enhance nutrient contents in plants, thereby leading to better growth and resistance under stress.
A potted plants experiment was performed to evaluate the effects of B. mojavensis B1302 on wheat. This study previously revealed the capability of this strain to produce extracellular enzymes and detect PGP abilities. Therefore, this prompted us to further investigate the efficiency in vivo. In this study, wheat seeds treated with B1302 culture filtrate had higher germination rates than those in the control. The reason may be due to the synthesis of hormones such as IAA, which can trigger the activity of specific enzymes that promote early germination. In the potted plants experiment, the increased wheat height and fresh weight implied that the B1302 strain could play a role in promoting growth. Also, B. mojavensis B1302 strain exhibits a very good control efficacy compared to commercial fungicides. Then, the strain was tested for its impact on disease resistance of the pathogens in a pot trial. B. mojavensis B1302 culture filtrate could reduce the disease index. In addition, we examined the efficacies of culture filtrate and commercial fungicide. B1302 culture filtrate had a higher efficacy (65.25%) than that in the control group, and it showed that culture filtrate treatment effects did not vary significantly with the commercial fungicide. Therefore, B. mojavensis B1302 had better control effects against R. cerealis and is consistent with the antifungal effects in vitro.
However, since the microorganisms investigated in this research are from a natural source, they are anticipated to be harmless to humans. Given this, in the next step, we also carried out animal experiments to validate our findings. After two weeks of feeding and gavage with B1302 culture filtrate powder, all mice were alive and healthy. Furthermore, we also found that there was no distinct difference between the two groups in the organ index and serum biochemical index. Therefore, culture filtrate of
B. mojaves B1302 is safe, and is consistent reports that the antagonistic strain and its cultivation products are non-toxic [
54].